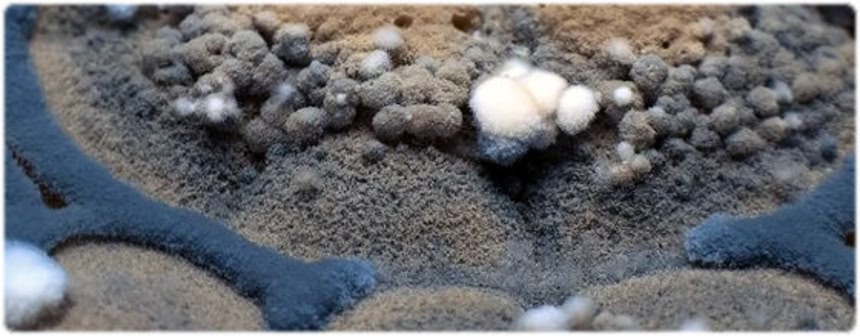

この画像を大きなサイズで見る
この画像を大きなサイズで見るAdvertisement
カビはいいやつもいれば悪いやつもいるわけで、人間の暮らしと切っては切れない間柄なんだけども、そんなカビの様子がよくわかる映像が紹介されていたよ。
ニコニコ動画にアップされていたんだけれど、もともとはVIMEOだったらしので、VIMEOの方のアドレスがわかるおともだちがいたら教えて欲しいんだ。
awaiさんありがとーVIMEOの映像が届いたよ。
こっちはサイエンスネットの科学映像館より、驚異の植物たちの映像
植物ってやっぱ凄いんだっていうのがわかっちゃうんだ。
📌 広告の下にスタッフ厳選「あわせて読みたい」を掲載中
















(・`ё・`)!?
神秘的すぎてワロタww
ダンゴムシを放してナウシカごっごしたい
カビさんたち、いつもいつもありがとう。お世話になってます。
どうか、私の部屋にはご遠慮ください。
座敷ワラシがもうお住みになってますので。
2つめと3つめの動画は何かいやらしいね
こういう世界でナウシカは大の字で寝そべったりしてるわけか
3つめの動画の赤い実みたいのは食ってみたいね、なんか柘榴みたいだ
今年はキノコが豊作だったな
八王子の里山でマツタケ見つけたぐらいだ
神様ありがとう
あらやんだ。
オイラのキノコも大元気
>>8
YOUR WELCOME!!(どういたしまして!!)
。。。すみません
赤や黄色がないと毒々しさが足りないね
カビってこんなに綺麗だったんだなあ
風の谷のナウシカ思い出した。腐海って不快だ。
生き残りをかけた努力 人間と同じ
>Your Welcome!
You’re welcome!!
でないのかな?
カビの世界に森を視つけたね。
植物の祖なのかな?菌類は。
おおお
生き物観察は好きだが、カビは観察したことがなかった。
なんじゃこりゃあ。すげーぜ。
>>15
you’reの方は少し古い
>ニコニコ動画にアップされていたんだけれど、もともとはVIMEOだったらしので、VIMEOの方のアドレスがわかるおともだちがいたら教えて欲しいんだ。
VIMEO
カビは地球の神秘を表している